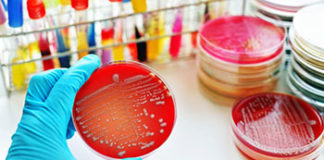
sepsa

Oznaka: učestalo mokrenje
Sepsa: Nije baš tako rijetka, a često se uopće ni ne...
Procjenjuje se da svakoga sata u svijetu 50 ljudi umire od sepse, a uzrokuje više smrti od raka prostate, raka dojke i HIV/AIDS-a. Podložniji...
Učestalo mokrenje
Saznajte kada je zapravo previše i koja su tri najčešća uzroka.Čest odlazak u toalet preko dana ili noći može biti znak problema u vašem organizmu....
Samo jedna injekcija na dan može smanjiti rizik od infarkta
Oboljeli u Hrvatskoj sad imaju mogućnost dobivanja lijeka koji čuva kardiovaskularno zdravlje, smanjuje pojavnost srčanog i moždanog udara za 13 posto te smanjuje arterijski...
Važne sigurnosne informacije za osobe s dijabetesom koje koriste NovoPen® Echo®
Novo Nordisk poziva korisnike inzulinske brizgalice NovoPen® Echo® iz jedne od zahvaćenih serija da zamijene ležište uloška, jer neki mogu biti oštećeni ili podložni...
Različiti simptomi indiciraju različite bolesti….
Žute izrasline oko očiju i još 8 čestih pojava kojima nas tijelo upozorava da nešto nije u redu. Različiti simptomi indiciraju različite bolesti ili...
Idite k lječniku
Ako osjetite neke od ovih simptoma, pripazite, možda je – dijabetes. Ako ste objektivno izloženi povećanom riziku, održavajte zdravu tjelesnu težinu i redovno se...